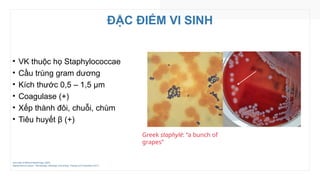
ĐẶC ĐIỂM VI SINH
• VK thuộc họ Staphylococcae
• Cầu trùng gram dương
• Kích thước 0,5 – 1,5 µm
• Coagulase (+)
• Xếp thành đôi, chuỗi, chùm
• Tiêu huyết β (+)
Color Atlas of Medical Bacteriology (2020)
Staphylococcus aureus – Microbiology, Pathology, Immunology, Therapy and Prophylaxis (2017)
Greek staphylé: “a bunch of
grapes”
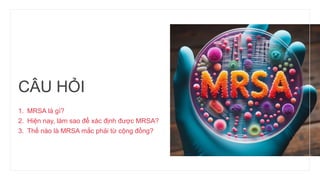
CÂU HỎI
1. MRSA là gì?
2. Hiện nay, làm sao để xác định được MRSA?
3. Thế nào là MRSA mắc phải từ cộng đồng?

Bài báo trình bày về đặc điểm vi sinh, cơ chế bệnh sinh và dịch tễ của Staphylococcus aureus, đặc biệt là chủng kháng methicillin (MRSA). Các phương pháp xác định MRSA và lựa chọn kháng sinh điều trị cũng được đề cập, bao gồm kháng sinh dành cho MSSA và MRSA, cùng với những khuyến cáo hiện tại từ các tổ chức y tế. Cuối cùng, bài báo cũng nêu rõ tầm quan trọng của việc theo dõi và điều trị kịp thời để quản lý nhiễm trùng do tụ cầu.

![IDSA (2014) – NHIỄM TRÙNG DA VÀ MÔ MỀM
Stevens DL, Bisno AL, Chambers HF, et al. Clin Infect Dis. 2015 May 1;60(9):1448. doi: 10.1093/cid/civ114. Dosage error in article text]. Clin Infect Dis. 2014;59(2):e10-e52. doi:10.1093/cid/ciu444](https://image.slidesharecdn.com/ieu-tri-ca-mrsa2-241122024107-4234b431/85/Di-u-tr-CA-MRSA-2-tttytytrtrtttttytt-26-320.jpg)














